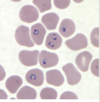
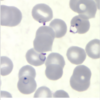
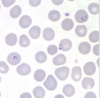
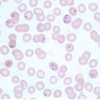
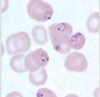
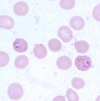
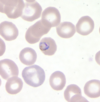
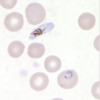
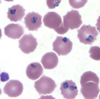
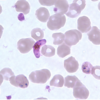
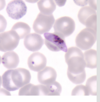
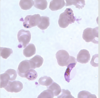
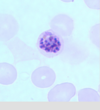
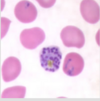
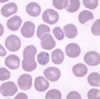
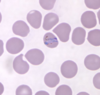
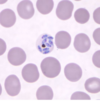
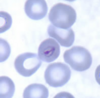
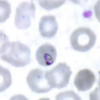
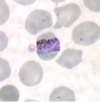
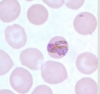
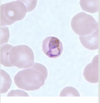
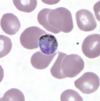
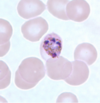
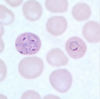
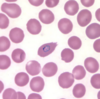
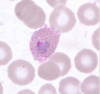
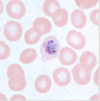
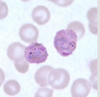
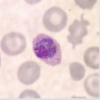
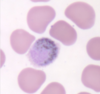
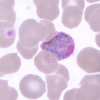
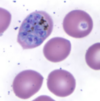
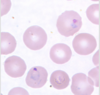
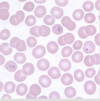
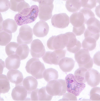
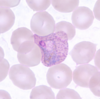
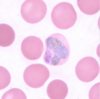
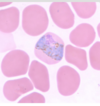
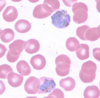
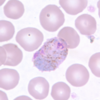
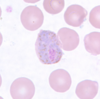
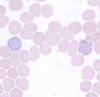
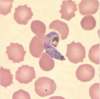
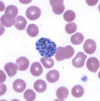
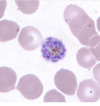
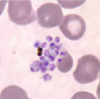
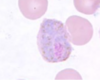
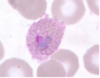
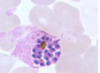
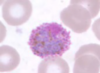
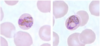
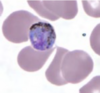
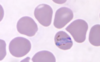
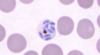
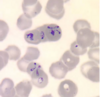

Which disease transmission intensity can be measured by rates of splenomegaly? Other infections commonly causing massive splenomegaly?
- Malaria - hyperreactive malarial splenomegaly (due to recurrent infections)
- Schistosomiasis, visceral Leishmaniasis
hyperreactive malarial splenomegaly pathophysiology? Sx? Who is it dangerous in?
- Repeated infections -> overproduction on IgM. These removed by spleen which enlarges
- Spleen >10cm below costal margin, anaemia, abdo discomfort
- Pregnant - may get acute haemolysis
Hyperreactive malarial splenomegaly diagnosis? How to differentiate from lymphoma? Rx?
- Spleen >10cm below costal margin and reduces in size by 40% on antimalarial treatment
- Younger (usually <40) lymphocyte count more normal
- Chloroquine
Where has >90% vivax? Falciparum?
- Central America/ West Coast South America/ China
- Falciparum - Sub saharan Africa
Malaria life cycle. Form injected and what do these do?
Which infects RBCs?
Which is taken up by other mosquitos? Life cycle within mosquitos? How long does it last?
What form in only vivax and ovale?
- Sporozoites - infect hepatocytes and mature into schizonts (containing merozoites) which rupture.
-[Vivax and ovale some from this initial infection form hepatic hypnozoites] - Merozoites infect RBCs (as these mature in RBC form immature ring shaped trophozoites which go on to either
Produce:
- Gametocytes (male and female) taken up by mosquitos ) - to form ookinite then oocyst then oocytes in anopheles gut wall
- 10 days
Or Form mature trophozoite in RBC which turns into RBC shizon which then ruptures releasing more merozoites
- Hypnozoites
Why is falciparum more severe?
- Cytoadherance - Bind to endothelial cells in capillaries of organs -> prevents effective removal of infected cells by spleen
- Increased sequestration
- Also replicates faster
Which rbc antigen protects against vivax
- Duffy negative
Aspects of severe Malaria
Any 1 of:
- Anaemia <70g/L together with parasite count>10,000/µL
-or <50g/L in kids - Acidosis pH <7.3, bicarb <15, lactate >5
- Hypoglycaemia <2.2 mmol (<40 mg/dl)
- seizures >2,
- GCS <11
- Renal impairment Cr >265µmol/L (3 mg/dL)
- Bilirubin >50 µmol/L (3 mg/dL) together with a parasite count>100,000/µL
- Pulm oedema
- Shock (<80mmHg)
- Bleeding
- Hyperparasataemia >10%
- Black urine
Name 2 contributing factors for hypoglycaemia in Malaria
- Impaired hepatic gluconeogenesis
- Glucose consumption by parasites
- Quinine - stimulates pancreatic insulin secretion
Seen on fundoscopy of cerebral Malaria
White patches on retina (due to focal ischaemia) and haemorrhage
white-centred haemorrhages, a superficial blot haemorrhage at the fovea, mild macular whitening (black arrow) and cotton wool spot (white arrow)

Which Malaria can cause malarial nephrosis in children?
- P malariae
- Immune complex - Causes nephrotic syndrome that Doesn’t respond to steroids or Malaria eradication
Rbc on slide - looks like pair of headphones inside is typical of ?
Falciparum - actually 2 chromatin dots
Thick and thin blood films mainstay of dx for Malaria. Rapid diagnostic test can be used. What might a RDT look for? Which one specific to falciparum?
- pLDH (plasmodium LDH)
- HRP-2 (histidine rich protein 2) - falciparum
Which antimalarial most potent (fastest drop in parasite count)? Why often given in combination? Example Combination?
- Artensunate
- Can be given IV PR or oral
- Short half life *1hr and so often used in combination with other drugs ‘arteminism combination therapy’ as otherwise would need 7 day course.
- Artemether-lumefantrine
Which Quinine no longer recommended for p falcipaum
Chloroquinine - high levels of resistance
Which antimalarial for vivax and ovale in addition to choroquine? What do you need to screen for
- Primaquine 30mg for 14 days (15mg for ovale)
- G6PD
Rx of uncomplicated faciparum?
Artemisinin combination therapy 3-days
Eg Artemether/Lumefantrine
Rx severe falciparum
IV artesunate
Malaria in pregnancy rx
Still ACT
A-Lumefantrine first line
[But not A-co-trimox or A-pyronaridine]
Best evidence vector control for Malaria (2 things)
- Insecticide treated nets
- Residual indoor spraying
Malarone is? How does it work? How does this affect length of treatment when used for prophylaxis?
- Atovaquone-proguanil
- Prevents formation of schizonts ‘causal prophylaxis’
- Most other agents kill blood stage schizonts - ‘suppressive prophylaxis’
- Therefore only need Malarone for 1 week after leaving but others need to keep taking for 1 month
Malaria vector
Anopheles
Malaria reservoir
Humans
Where does the sexual multiplcation of malaria take place
In mosquitos -> form sporozoites